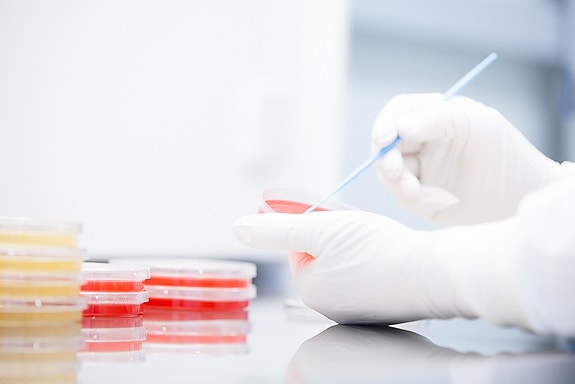
Bilde 3 av 4 i jobbannonse-galleriet

Inaktiv
Fabrikksjef
Curida AS
- Frist Snarest
Vil du være med å utvikle fremtidens fabrikk
Vil du være med å utvikle fremtidens fabrikk, til det som statsminister Erna Solberg og flere andre har utpekt som et nytt norsk industrieventyr?
Curida er inne i en fase der solid og lønnsom drift ved fabrikken i Elverum skal kombineres med realisering av omfattende og spennende vekstmuligheter. Til å inneha en nøkkelrolle i dette arbeidet søker vi fabrikksjef for fabrikken i Elverum. Fabrikken er i dag en hjørnestensbedrift i Elverum, og har over 100 ansatte. Curida produserer sterile og ikke-sterile, flytende legemidler. Over 80 % av produksjonsvolumet eksporteres til mer enn 80 land.
Du vil inngå i Curidas ledergruppe og får totalansvaret for drift og utvikling av fabrikken. Dersom du har en sterk kommersiell legning, er en ambisiøs, tydelig og erfaren leder og er i stand til å skape og utvikle et vinnerteam, så hører vi gjerne fra deg.
Sentrale ansvars- og arbeidsoppgaver:
- Overordnet kommersielt ansvarlig for lønnsom og forsvarlig drift av fabrikken på Elverum
- Ansvar for fabrikkens kvalitets- og leveransesystem inkl. budsjett. Personal- og resultatansvar
- Digitalisere og effektivisere fabrikken, samt legge til rette for utvidelse av dagens produktportefølje i årene fremover
- Bidra til Curidas vekst og måloppnåelse, med fokus på samhandling mellom produksjon og forretningsutvikling
- Sikre at fabrikken til enhver tid har en formålstjenlig organisering, beredskap og kompetanse
- Være en aktiv pådriver for et godt og effektivt samarbeid på tvers av avdelinger
- Ansvar for å delta sammen med selgerne for å harmonisere kundenes krav og forventninger med fabrikkens muligheter
Ønsket bakgrunn og erfaring:
- Relevant høyere utdanning
- Erfaring innenfor industriell produksjon
- Ledererfaring fra produksjonsmiljø med fokus på kvalitet og nullfeil-produksjon
- Erfaring med endringsledelse.
- Interesse for og kjennskap til farmasøytisk industri er en fordel
- Selvstendig og beslutningsvillig, med evne til å stille krav.
- Evner å motivere og utvikle medarbeidere.
Vi ser etter en ambisiøs og tydelig leder med naturlig autoritet. Du er en jordnær og tillitsskapende person, med entusiasme og evne til å inspirere andre rundt deg. Du må være utviklingsorientert og se selskapsperspektivet. Gode kommunikasjonsevner er en forutsetning. Arbeidsspråket på fabrikken er norsk, men kommunikasjon med internasjonale kunder foregår på engelsk.
Vi tilbyr en helt sentral rolle i et vekstselskap med lite byråkrati og raske beslutningsveier.
Gode betingelser, medeierskap og eventuell bistand til flytting tilbys den riktige kandidat.
JobbMatch
Er du en god match for denne stillingen?
JobbMatch ser på erfaringen og egenskapene dine – og sjekker hvor godt du passer.
Om arbeidsgiveren
Fabrikken er i dag en hjørnestensbedrift i Elverum, og har over 100 ansatte. Curida produserer sterile og ikke-sterile, flytende legemidler. Over 80 % av produksjonsvolumet eksporteres til mer enn 80 land.Curida er inne i en fase der solid og lønnsom drift ved fabrikken i Elverum skal kombineres med realisering av omfattende og spennende vekstmuligheter. Til å inneha en nøkkelrolle i dette arbeidet søker vi fabrikksjef for fabrikken i Elverum.
- Sted: Solbærvegen 5, 2409 Elverum
- Bransje: Farmasi og legemiddel, Industri og produksjon
- Stillingsfunksjon: Helsepersonell, Ledelse
Nøkkelord
Fabrikkledelse, Produksjonsledelse, Farmasøytisk Industri, Ledelse, fabrikksjef
(1/4)
Annonseinformasjon
- FINN-kode 200602427
- Sist endret